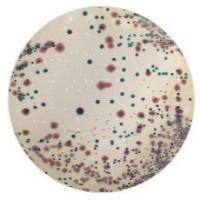

为什么有的人容易患尿路感染?
互联网
容易患尿路感染的人基本上都是女性,指的是经常反复发作的尿路感染。Stamey等观察到,反复发作尿路感染的妇女,在阴道口粘膜上有肠道细菌和粪链球菌。这些妇女在作阴道口细菌培养时,有57%为革兰氏阴性杆菌,细菌培养计数为105 /毫升以上,并可以生存较长时间。对照组都远远低于这些数字。发生尿路感染后,尿液培养的细菌与阴道口的细菌相同。Stamey认为,一个妇女经过3次连续阴道口细菌培养计数超过正常,可以作为尿路感染反复发作的证据。对阴道口分泌物pH值的测定,认为与该处细菌移生和生长有着重要的关系。阴道口pH值较高有利于细菌生长,较低可以抑制细菌生长。反复发作尿路感染的妇女,其阴道粘膜细胞对细菌的粘附力大大增高。阴道口细菌的增多与个人卫生、阴道分泌物多少及有无性交和性交次数的多少等因素无关。如果阴道口有显著的细菌移生,则可出现尿道的细菌移生。由于上述的原因,细菌可以逆行上升到膀胱或肾盂。而且,有人发现,尿路反复发作感染的妇女与正常妇女尿道内均有较多的致病菌,越靠近尿道外口细菌越多。
根据上述情况说明,尿路感染的主要发病因素不是尿道内有无致病菌,而是个体对细菌的易感程度。易感程度低的人不易患尿路感染,易感程度高的人容易患尿路感染。